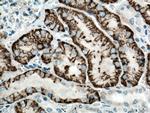
SLC4A4 Antibody in Immunohistochemistry (Paraffin) (IHC (P))

Search
Proteintech
SLC4A4 Polyclonal Antibody
{{$productOrderCtrl.translations['antibody.pdp.commerceCard.promotion.promotions']}}
{{$productOrderCtrl.translations['antibody.pdp.commerceCard.promotion.viewpromo']}}
{{$productOrderCtrl.translations['antibody.pdp.commerceCard.promotion.promocode']}}: {{promo.promoCode}} {{promo.promoTitle}} {{promo.promoDescription}}. {{$productOrderCtrl.translations['antibody.pdp.commerceCard.promotion.learnmore']}}
产品信息
11885-1-AP
种属反应
已发表种属
宿主/亚型
分类
类型
抗原
偶联物
形式
浓度
规格
纯化类型
保存液
内含物
保存条件
运输条件
产品详细信息
Immunogen sequence: LRVVQPMFN HSIFTSAVSP AAERIRFILG EEDDSPAPPQ LFTELDELLA VDGQEMEWKE TARWIKFEEK VEQGGERWSK PHVATLSLHS LFELRTCMEK GSIMLDREAS SLPQLVEMIV DHQIETGLLK PELKDKVTYT LLRKHRHQTK KSNLRSLADI GKTVSSASRM FTNPDNGSPA MTHRNLTSSS LNDISDKPEK DQLKNKFMKK LPRDAEASNV LVGEVDFLDT PFIAFVRLQQ AVMLGALTEV PVPTRFLFIL LGPKGKAKSY HEIGRAIATL MSDEVFHDIA YKAKDRHDLI AGIDEFLDEV IVLPPGEWDP AIRIEPPKSL P (25-354 aa encoded by BC030977)
靶标信息
Slc4a4 encodes a sodium bicarbonate cotransporter (NBC) involved in the regulation of bicarbonate secretion and absorption and intracellular pH. Slc4a4 is an electrogenic sodium/bicarbonate cotransporter with a Na(+):HCO3(-) stoichiometry varying from 1:2 to 1:3. Moreover, Slc4a4 may regulate bicarbonate influx/efflux at the basolateral membrane of cells and regulate intracellular pH. Isoform 2: May have a higher activity than isoform 1. Mutations in the Slc4a4 gene are associated with proximal renal tubular acidosis. Multiple transcript variants encoding different isoforms have been found for the Slc4a4 gene. Diseases associated with SLC4A4 include Renal Tubular Acidosis, Proximal, With Ocular Abnormalities and Proximal Renal Tubular Acidosis.
仅用于科研。不用于诊断过程。未经明确授权不得转售。
生物信息学
蛋白别名: electrogenic Na/bicarbonate cotransporter NBCe1-C; Electrogenic sodium bicarbonate cotransporter 1; electrogenic sodium bicarbonate cotransporter NBCe1 variant D; HNBC 1; kidney type Na+/HCO3- cotransporter; kNBC 1; kNBC1; Na(+)/HCO3(-) cotransporter; Na+:HCO3- cotransporter; Na+HCO3- cotransporter 4; NBC 1; NBC 2; NBC isoform; electrogenic; NBC-like protein; NBCE 1; OTTHUMP00000160355; OTTHUMP00000218884; OTTHUMP00000218885; pancreas sodium bicarbonate cotransporter; pancreatic sodium bicarbonate cotransporter; Sodium bicarbonate cotransporter; sodium bicarbonate cotransporter 1 (sodium bicarbonate cotransporter, kidney; sodium bicarbonate cotransporter, pancreas); solute carrier family 4 (anion exchanger), member 4; solute carrier family 4 (sodium bicarbonate cotransporter), member 4; Solute carrier family 4 member 4; solute carrier family 4, member 4; solute carrier family 4, sodium bicarbonate cotransporter, member 4; solute carrier family 4, sodium bicarbonate cotransporter, member 4, brain type; solute carrier family 4, sodium bicarbonate cotransporter, member 5
基因别名: AI835705; HHNMC; HNBC1; KNBC; kNBC1; NBC; NBC1; NBC2; Nbc4; NBCE1; NBCe1-A; PNBC; PRTAO; Rnbc1; SLC4A4; SLC4A5
UniProt ID: (Human) Q9Y6R1, (Mouse) O88343, (Rat) Q9JI66
Entrez Gene ID: (Human) 8671, (Mouse) 54403, (Rat) 84484